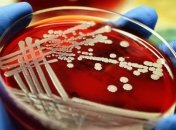
Создали первое в мире масло, способное убить смертельную бактерию

Новости по теме Бактерии
-

Биоинженеры знаменитого Массачусетского технологического института (MIT) заявили о том, что разработали специальный "язык программирования" для живых клеток.
-

В ходе эксперимента было замечено, что кишечная палочка погибла всего спустя пять секунд, а две другие - спустя 25 секунд.
-

Частица при этом может эффективно поглощать излучение и выделять большое количество тепла.
-

С помощью такого безотходного производства ученые планируют помогать бедным странам третьего мира.
-

Энергию данные организмы получают посредством фотосинтеза, для чего необходимы фотоны света.
-

По словам старшего преподавателя Сибирского медицинского госуниверситета Надежды Келус, об антибактериальных свойствах мха известно давно.
-

Существуют несколько популяций микроорганизмов, часть которых отвечает за накопление жира в летний период.
-

Появление таких отрицательных явлений воздействует на качество существования всех живых организмов, населяющих планету Земля.
-

Этот препарат устойчивый к воздействию других лекарств и борющийся с бактериями superbug.
-

Ученые официально подтвердили пользу бороды для мужского здоровья.
-

Палеопатологи расшифровали геном бактерии, которой более пяти тысяч лет.
-

Общение насекомых происходит посредством химических веществ – феромонов, некоторые из которых активно изучаются.
-

В момент нападения на противника бактерия использует "щит" из ферментов, чтобы не погибнуть в результате собственной атаки.
-
На основе льняного масла разработали противомикробное средство, способное убивать смертельную бактерию – золотистый стафилококк.
-

В результате последних наблюдений за жизнедеятельностью бактерий ученые пришли к выводу о наличии у микроорганизмов способности к интиму.
-

Ученые научились использовать слизевики для моделирования дорожных сетей, а бактерии - "обучать" фермерству.

